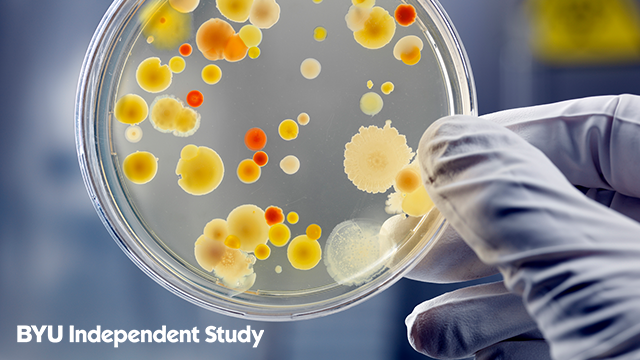

Whether you’re interested in studying the many facets of biological science or simply need to complete your GE science credits, the list of suggested courses below is full of new, interactive online course options.
MMBIO 121: General Biology: Health and Disease
In the new MMBIO 121, you will learn about the living world and how it functions and adapts, particularly in relation to human health and disease. It delves into the fascinating world of cells (human and bacterial) and find out what makes them tick. Lecture videos, great online resources, helpful hints and tips, and lots of writing opportunities make this course a fun and robust learning experience. If you have ever wondered about how diseases work, how they affect humans, and the techniques scientists use to reveal their secrets, this is the course for you! You will never view washing your hands as a waste of time again!
MMBIO 221: General Microbiology
What you can't see could kill you or make you sick. What you can’t see can also defend you from the microscopic enemies that are trying to damage your body, help you digest your food, and break down organic matter so you can grow delicious veggies in your garden. In MMBIO 221, you will learn about these microscopic friends and foes—and much, much more! We have updated this course to the newest and most exciting edition of the textbook, and it now includes fascinating and entertaining lecture videos. Take MMBIO 221 and see the microscopic world in a whole new way!
MMBIO 240: Molecular Biology
In a world too small to see, minuscule machines slave away to keep you alive—while others try to kill you! Enter a world of excitement and intrigue as you learn about proteins, DNA, viruses, and the molecular mechanisms that make living things work. You will also learn about what can go wrong and the results of those molecular misadventures. MMBIO 240 is a brand-new course with a dynamic and entertaining instructor.
CELL 120: General Biology
The new CELL 120 emphasize the scientific method, cell theory, biochemical unity, the central dogma, bioenergetics, reproduction, and evolutionary theory. Not only is this a GE course, but also you will come away with critical thinking skills and a great foundation for all of your future scientific interests.
CELL 210: Human Anatomy (with Virtual Lab)
In this 100% newly revised course, the BYU Cell Biology and Physiology department has created videos to guide you through all of the remarkable parts of the human body. Students also have their own personal TAs teach them anatomical parts in the virtual human anatomy lab. The laboratory manual helps guide and focus students' study, and the online exams covering the anatomical parts are now in color! The textbook also has a wealth of excellent interactive media and assessments for practice. CELL 210 is lots of fun for the not-so-faint of stomach!
BIO 165: Introduction to Bioinformatics
What do biology, ecology, genetics, vast amounts of data, and supercomputers have in common? You will find out in our new bioinformatics course. Learn how to write programs to analyze data and answer scientific questions that have been a mystery until now.
